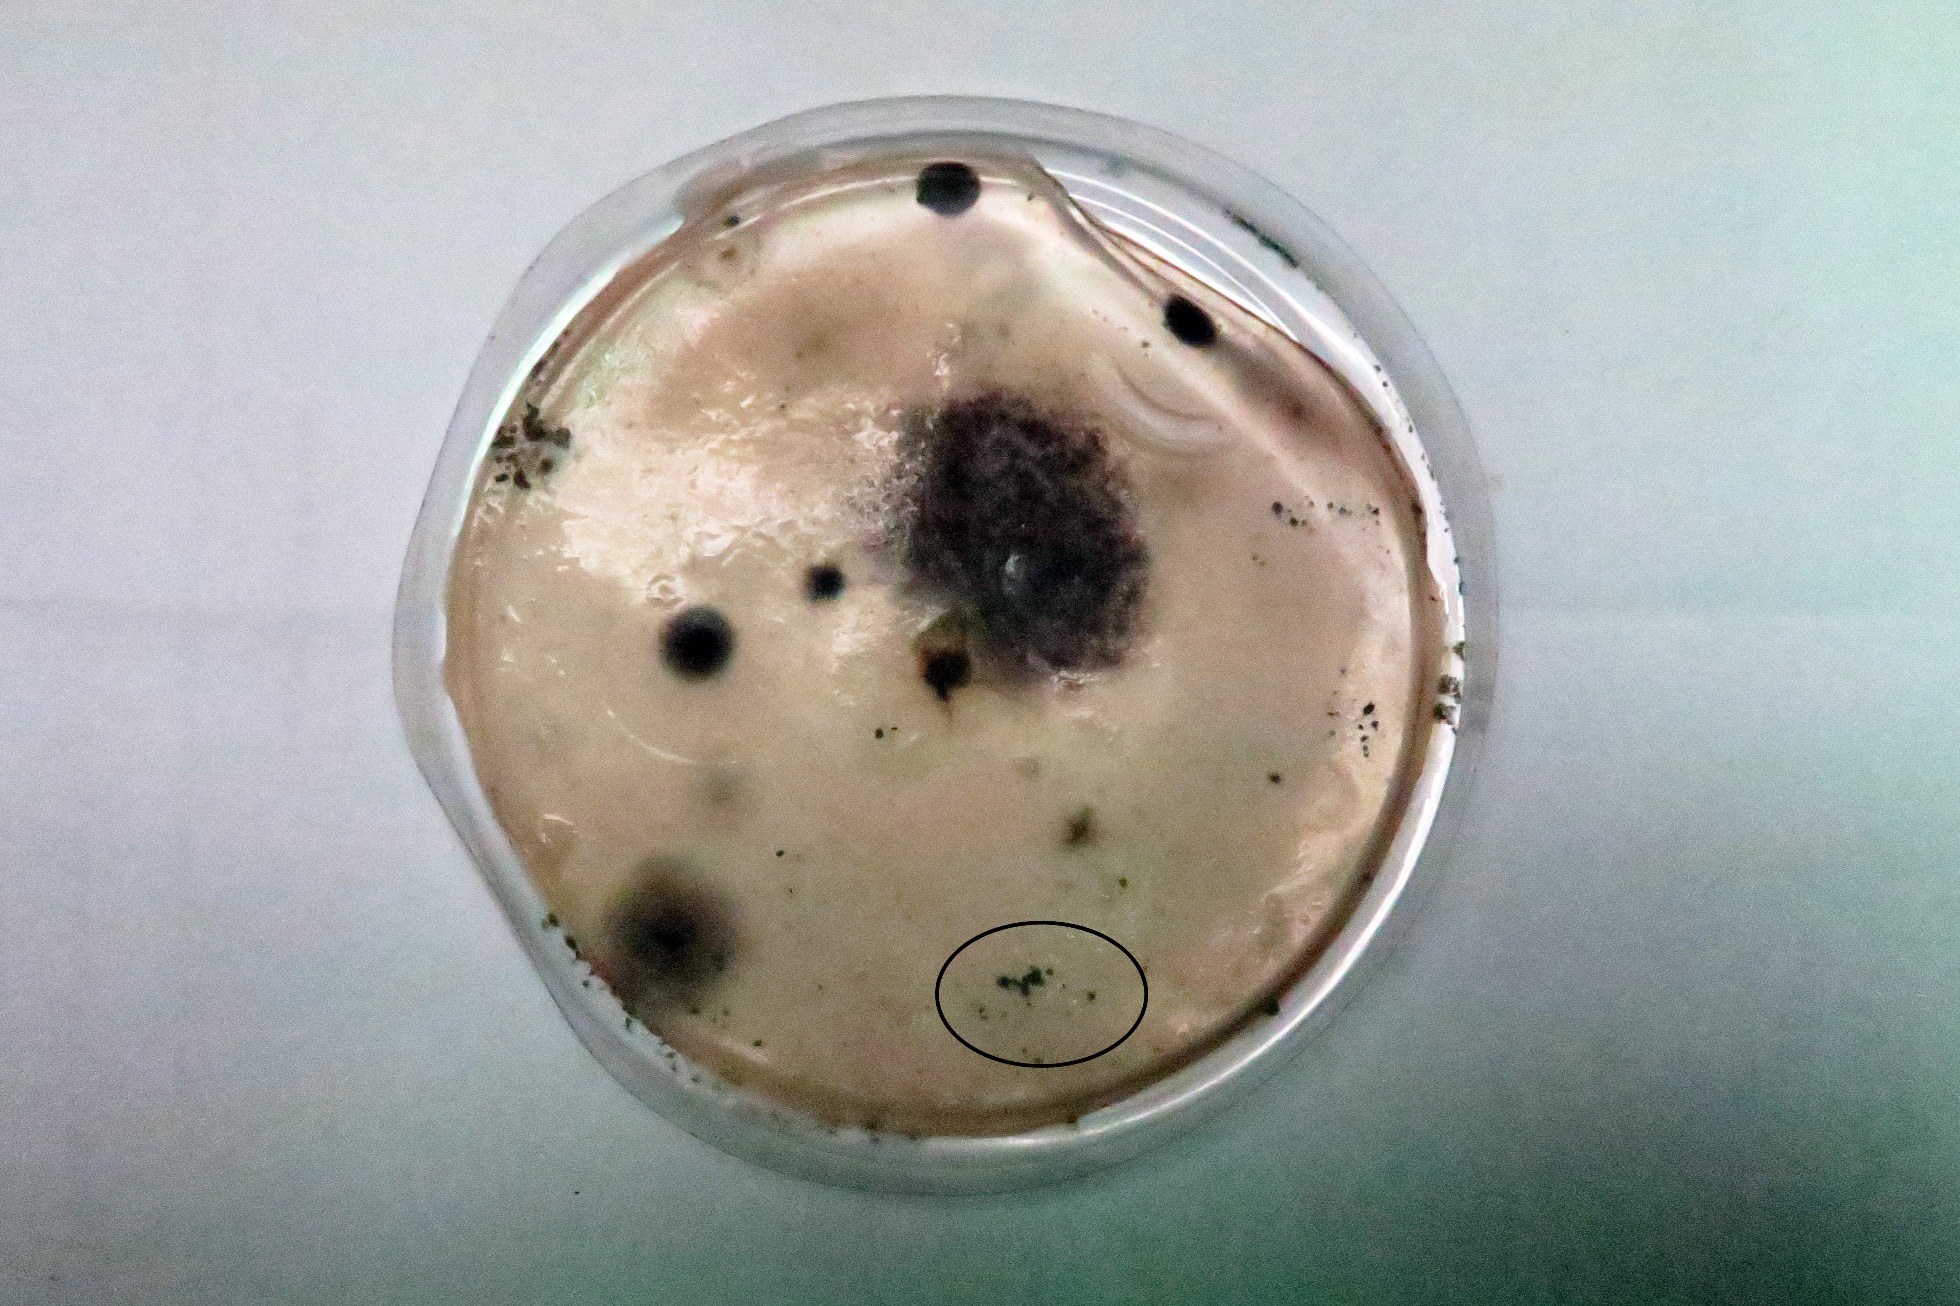

Physarum polycephalum y tres mas de rebote.
Physarum polycephalum y tres mas de rebote.
- Josep Torres
-
 Autor del tema
Autor del tema
- Fuera de línea
- Moderador
-

Menos
Más
- Mensajes: 8745
- Gracias recibidas: 8379
7 años 9 meses antes - 7 años 9 meses antes #99457
por Josep Torres
Physarum polycephalum y tres mas de rebote. Publicado por Josep Torres
Hola a tod@s.
Hoy os presento un trabajo en el que ya llevo 15 meses con él.
Empieza con un Mixomiceto en fase plasmodial fotografiado sobre un pequeño tronco degradado en un bosque de robles el 17 de Abril del pasado año 2017.
Physarum polycephalum (probablemente)
De color anaranjado y de aspecto gelatinoso.
Una ampliación del mismo.
En su microscopía aparecen un gran número de células que al parecer absorben y fagocitan bacterias.
Las células ameboides a 400 aumentos.
A 1000 aumentos multiplicándose al parecer por división celular simple.
Las mismas en reactivo de Melzer en fase de división celular.
En este momento y aprovechando que estaba practicando unos cultivos con Agar agar a dos especies de Haplotrichum, hice una prueba con el Agar agar restante que tenía en un recipiente rectangular, con un trozo del plasmodium encontrado.
El mismo a las 24 horas de su inoculación, en este caso ya se estaban fusionando las células para transformarse en una masa plasmodial.
Células fusionándose.
Plasmodium a 1000 aumentos.
Imágen a las 36 horas del mismo.
Aquí ya empiezan a formarse esférulas.
Estas esférulas se producen en circunstancias adversas y sirven para poder desarrollar nuevos cuerpos en el futuro y cuando las condiciones sean más óptimas.
Y por último una imágen a las 48 horas (una vida muy corta), aquí ya aparecen granulos globosos y cerebriformes en el plasmodium.
En ellos ya pude constatar la formación de las primeras esporas.
Solo muy pocas esporas como la remarcada en el círculo, de un tamaño muy por encima de las esférulas.
No pude observar en todo el proceso ninguna célula flagelada como las que se describen en la bibliografía de la especie.
Hoy os presento un trabajo en el que ya llevo 15 meses con él.
Empieza con un Mixomiceto en fase plasmodial fotografiado sobre un pequeño tronco degradado en un bosque de robles el 17 de Abril del pasado año 2017.
Physarum polycephalum (probablemente)
De color anaranjado y de aspecto gelatinoso.
Una ampliación del mismo.
En su microscopía aparecen un gran número de células que al parecer absorben y fagocitan bacterias.
Las células ameboides a 400 aumentos.
A 1000 aumentos multiplicándose al parecer por división celular simple.
Las mismas en reactivo de Melzer en fase de división celular.
En este momento y aprovechando que estaba practicando unos cultivos con Agar agar a dos especies de Haplotrichum, hice una prueba con el Agar agar restante que tenía en un recipiente rectangular, con un trozo del plasmodium encontrado.
El mismo a las 24 horas de su inoculación, en este caso ya se estaban fusionando las células para transformarse en una masa plasmodial.
Células fusionándose.
Plasmodium a 1000 aumentos.
Imágen a las 36 horas del mismo.
Aquí ya empiezan a formarse esférulas.
Estas esférulas se producen en circunstancias adversas y sirven para poder desarrollar nuevos cuerpos en el futuro y cuando las condiciones sean más óptimas.
Y por último una imágen a las 48 horas (una vida muy corta), aquí ya aparecen granulos globosos y cerebriformes en el plasmodium.
En ellos ya pude constatar la formación de las primeras esporas.
Solo muy pocas esporas como la remarcada en el círculo, de un tamaño muy por encima de las esférulas.
No pude observar en todo el proceso ninguna célula flagelada como las que se describen en la bibliografía de la especie.
Última Edición: 7 años 9 meses antes por Josep Torres.
El siguiente usuario dijo gracias: Juan Andrés Román
Por favor, Identificarse para unirse a la conversación.
- Josep Torres
-
 Autor del tema
Autor del tema
- Fuera de línea
- Moderador
-

Menos
Más
- Mensajes: 8745
- Gracias recibidas: 8379
7 años 9 meses antes #99458
por Josep Torres
Respuesta de Josep Torres sobre el tema Physarum polycephalum y tres mas de rebote.
Seguimos.....................
En este punto y ya a 23 de Mayo del pasado año, decidí cultivarlo en un recipiente con hojas de roble degradadas y humedecidas.
Entre el 23 de Mayo y el 2 de Junio de 2017 pude comprobar varios brotes del mismo en el interior del recipiente.
Las imágenes:
Y una ampliación del mismo:
En la microscopía de los mismos no pude observar nada distinto a lo ya mostrado.
A partir del 2 de Junio ya dejo de brotar secándose completamente a pesar de que seguía conservando la temperatura y humedad para su desarrollo, es como si la especie fuera inteligente y se hubiera dado cuenta de la situación.
Ya el 9 de Diciembre y obsesionado con completar el estudio de la misma, de nuevo preparé una placa con Agar agar e inoculé restos del mismo del recipiente con las hojas de roble.
Placa con Agar agar y el mixomiceto en su centro.
En este caso el fracaso fue total, no volvió ya a brotar y tuve que ya dar por muerta la especie.
Como ya estaba todo perdido dejé la placa a modo de cebo, a las 3 semanas (31 de Diciembre de 2017), en la misma pude observar por lo menos 3 hongos distintos:
Una Alternaria:
La placa a las 3 semanas y la mancha de Alternaria marcada con un círculo.
Ampliación de la misma.
Conidióforos y conidios a 400 aumentos.
Conidios a 1000 aumentos.
Por la morfología de estos muy probablemente se trate de una Alternaria de la Sección Pseudoulocladium, dentro de estas y por las medidas de los conidios con la que mejor encaja es con la Alternaria aspera, como que en estos casos resulta imposible el asegurar algo sin un análisis molecular y dado que cada día aparecen nuevos taxones, lo dejo como Alternaria aff. aspera.
La medida de los conidios en este caso 17,8;22,5 X 9,3;13,6 micras.
Aureobasidium aff. pullulans
Los círculos ya mas pequeños y bien delimitados.
Una ampliación de los mismos:
Conidióforos a 1000 aumentos.
Conidios a 1000 aumentos.
Esta especie se considera abundante sobre las hojas degradadas de nuestros bosques así como en nuestros hogares el las zonas húmedas como baños y cocina.
Este dato puedo corraborarlo ya que ayer mismo me encontré con algo muy parecido aquí en el Continente Americano y sobre una hoya ya muy degradada de planifolio.
Imágen de lo que probablemente se trate de la misma especie.
Y para terminar y en la misma placa:
Trichoderma viride
La mancha pequeña marcada con un círculo, este es todo un clásico que ya me he encontrado en otras ocasiones.
Sus típicos conidióforos a 1000 aumentos.
Conidios de pequeño tamaño, globosos y con unas medidas de entre 2,3 a 3,2 micras.
Saludos a tod@s.
En este punto y ya a 23 de Mayo del pasado año, decidí cultivarlo en un recipiente con hojas de roble degradadas y humedecidas.
Entre el 23 de Mayo y el 2 de Junio de 2017 pude comprobar varios brotes del mismo en el interior del recipiente.
Las imágenes:
Y una ampliación del mismo:
En la microscopía de los mismos no pude observar nada distinto a lo ya mostrado.
A partir del 2 de Junio ya dejo de brotar secándose completamente a pesar de que seguía conservando la temperatura y humedad para su desarrollo, es como si la especie fuera inteligente y se hubiera dado cuenta de la situación.
Ya el 9 de Diciembre y obsesionado con completar el estudio de la misma, de nuevo preparé una placa con Agar agar e inoculé restos del mismo del recipiente con las hojas de roble.
Placa con Agar agar y el mixomiceto en su centro.
En este caso el fracaso fue total, no volvió ya a brotar y tuve que ya dar por muerta la especie.
Como ya estaba todo perdido dejé la placa a modo de cebo, a las 3 semanas (31 de Diciembre de 2017), en la misma pude observar por lo menos 3 hongos distintos:
Una Alternaria:
La placa a las 3 semanas y la mancha de Alternaria marcada con un círculo.
Ampliación de la misma.
Conidióforos y conidios a 400 aumentos.
Conidios a 1000 aumentos.
Por la morfología de estos muy probablemente se trate de una Alternaria de la Sección Pseudoulocladium, dentro de estas y por las medidas de los conidios con la que mejor encaja es con la Alternaria aspera, como que en estos casos resulta imposible el asegurar algo sin un análisis molecular y dado que cada día aparecen nuevos taxones, lo dejo como Alternaria aff. aspera.
La medida de los conidios en este caso 17,8;22,5 X 9,3;13,6 micras.
Aureobasidium aff. pullulans
Los círculos ya mas pequeños y bien delimitados.
Una ampliación de los mismos:
Conidióforos a 1000 aumentos.
Conidios a 1000 aumentos.
Esta especie se considera abundante sobre las hojas degradadas de nuestros bosques así como en nuestros hogares el las zonas húmedas como baños y cocina.
Este dato puedo corraborarlo ya que ayer mismo me encontré con algo muy parecido aquí en el Continente Americano y sobre una hoya ya muy degradada de planifolio.
Imágen de lo que probablemente se trate de la misma especie.
Y para terminar y en la misma placa:
Trichoderma viride
La mancha pequeña marcada con un círculo, este es todo un clásico que ya me he encontrado en otras ocasiones.
Sus típicos conidióforos a 1000 aumentos.
Conidios de pequeño tamaño, globosos y con unas medidas de entre 2,3 a 3,2 micras.
Saludos a tod@s.
El siguiente usuario dijo gracias: Juan Andrés Román, Jon Joseba Arnedo
Por favor, Identificarse para unirse a la conversación.
- Juan Andrés Román
-

- Fuera de línea
- Spammer
-

Menos
Más
- Mensajes: 2558
- Gracias recibidas: 2756
7 años 9 meses antes #99459
por Juan Andrés Román
Respuesta de Juan Andrés Román sobre el tema Physarum polycephalum y tres mas de rebote.
Bueno bueno a estas le has hecho de todo y con una enorme insistencia 
Un saludo.
Un saludo.
El siguiente usuario dijo gracias: Josep Torres
Por favor, Identificarse para unirse a la conversación.
- Josep Torres
-
 Autor del tema
Autor del tema
- Fuera de línea
- Moderador
-

Menos
Más
- Mensajes: 8745
- Gracias recibidas: 8379
7 años 9 meses antes #99474
por Josep Torres
Respuesta de Josep Torres sobre el tema Physarum polycephalum y tres mas de rebote.
Gracias Juan Andrés, desde mi infancia siempre me han gustado los experimentos  .
.
Un abrazo
Un abrazo
El siguiente usuario dijo gracias: Juan Andrés Román
Por favor, Identificarse para unirse a la conversación.
Tiempo de carga de la página: 0.292 segundos

Foro de micología